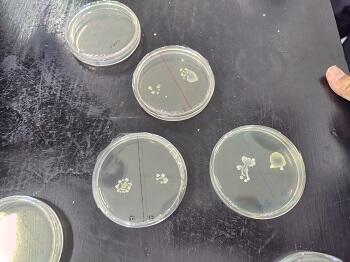

2024年5月の記事一覧
【マリン校舎】(食品系)サバ味噌煮缶詰実習 パート2
5月29日(水)
食品系では本日、「サバ味噌煮缶詰」の製造実習を行いました。
天草の牛深で獲れたサバを1匹1匹丁寧にさばき、マリン校舎秘伝のみそ調味液で味付けをしたサバ味噌煮缶詰はとても人気があり、販売をすればすぐに売り切れてしまう商品です!
マリン祭や地域の各種イベントの販売に向けてこれから製造実習を行って行きますので、マリン校舎食品系の製品を見かけた際にはぜひお買い求めください!
| 〇サバ味噌煮缶詰の製造工程〇 | |
 |
 |
| サバをさばいています | サバのひれをハサミで切ります |
 |
 |
| サバを缶の高さに合わせてカットします | サバを計量して缶に詰めます |
 |
|
| サバ味噌煮缶詰の完成品! | |
【マリン校舎】(食品系)ツナカレー製造実習
5月28日(火)
本日食品系では、人気商品の「ツナカレー」の製造実習を行いました。
キハダマグロが原料の「ツナ」を使用したツナカレーは幅広い年代の方に愛される商品です!
ワインやケチャップなどで味を調えたカレールーは野菜やツナのうま味と相まって最高の逸品です!
本日作った製品は、3か月ほど熟成させてマリン祭や地域のイベント等で販売していく予定です。
見かけた際にはぜひお買い求めください!
| 〇ツナカレーの作り方〇 | |
 |
 |
| タマネギを炒めて煮込んでいきます | 具材をさいの目切りにします |
 |
 |
| 切った野菜を炒めていきます | 具材を既定量ずつに量っていきます |
 |
 |
| カレールーを袋に入れていきます | 出来上がったツナカレー |
【マリン校舎】(航海コース)熊本丸航海日誌 No.7
5月28日(火)~30日(木)
熊本丸は現在、熊本県樋合島沖に錨泊中です。
昨日は、天候も穏やかで風もなかったため順調な航海となりました!
またこの3日間の中では、長崎県の仲卸魚市場の見学を行いました。競りが終わった後の魚は、流通する前なのでスーパーで売られる時よりも安い値段で取引されています。生徒達は、水産流通について体験的な学びを行いました。
| 〇実習の様子〇 | |
| 28日(火)の様子 | |
 |
 |
| 29日(水)の様子 | |
 |
 |
| 30日(木)の様子 | |
 |
 |
【マリン校舎】(食品系)じもと探究EXPOでグランプリを受賞しました!
令和6年5月25日(土)
熊本県青年会議所主催「第57回熊本ブロック大会in水俣」がエコパーク水俣で開催され、食品系の生徒6名が参加しました。実習製品を販売したり、探究コンテストに参加したりするなど、県内各地の高校の魅力が存分に詰まったイベントでした。探究コンテストでは、「熊本のもったいないを特産品に」というテーマで、これまでの商品開発の取組を発表し、見事、グランプリを受賞することができました。投票していただいた皆様、ありがとうございました。
【マリン校舎】(航海コース)熊本丸航海日誌 No.6
5月25日(土)~27日(月)
熊本丸は現在、長崎県の三重式見港に停泊中です。
昨日は、午前中に船内で学習を行い、午後からは寄港地で自由時間を取りました。
また、この3日間の間には救命艇の降下、操縦訓練を行ったほか、釣獲実習で釣れたアジなどをさばく練習なども行いました!!
| 〇実習の様子〇 | |
| 〇25日(土)の様子 | |
 |
 |
| 26日(日)の様子 | |
 |
 |
| 27日(月)の様子 | |
 |
 |
【マリン校舎】(航海コース)熊本丸航海日誌 No.5
5月23日(木)~24日(金)
熊本丸は現在、長崎県の三重式見沖に錨泊中です。
天草の阿村沖から三角の狭い水路を通過して有明海から長崎に向けて航海しました。
錨泊中は見張りで周りの確認を行いながら、熊本丸の乗組員と船について話を行ったりして過ごしています。
| 〇実習の様子〇 | |
| 〇23日(木)の様子 | |
 |
 |
| 〇24日(金)の様子 | |
 |
 |
【マリン校舎】(航海コース)熊本丸航海日誌 No.4
5月21日(火)~22日(水)
熊本丸は現在、天草の阿村沖に錨泊中です。
昨日は、波も穏やかで船も少なかったため生徒達が熊本丸の舵を取りました!
操舵号令も覚えたようで、操作を間違えずにしっかりと操船を行いました。
この実習を通じて、生徒達は日々たくましく成長しています!
| 〇実習の様子〇 | |
| ●21日(火)の様子 | |
 |
 |
| ●22日(水)の様子 | |
 |
 |
【マリン校舎】(航海コース)熊本丸航海日誌 No.3
5月17日(金)~20日(月)
熊本丸は現在、熊本県の水俣沖に錨泊中です。
昨日は、天草の牛深の東側の狭い海域で釣り船が多く、注意の汽笛を鳴らしながらの航海となりましが予定よりも早く到着することができました。
またこの4日間の中には、(株)エムエスケイの第二十一松丸の見学も行いました。ブリッジだけではなく機関室など案内してもらい、普段の仕事の内容など説明していただき生徒達は興味津々でした。
| 〇実習の様子〇 | |
| 17日(金)の様子 | |
 |
 |
| 18日(土)の様子 | |
 |
 |
 |
 |
| 19日(日)の様子 | |
 |
 |
| 20日(月)の様子 | |
 |
 |
【マリン校舎】(食品系)チヌのスパイスカレー
5月16日(木)
食品系では、5月25日(土)に「第57回熊本ブロック大会in水俣」というイベントで製品販売を行います!!
そこで、本日はそこで販売を行う「チヌのスパイスカレー」の製造を行いました!!
マリン校舎食品系では数年前より、天草の名店「リトル・スパイス」の店主さんからスパイスの使い方について教わる「カレー講習会」を実施してきました。そこで学んだ知識を生かしてマリン校舎オリジナルの「スパイスカレー」を開発しています。
また、今回のカレーに使用するチヌは八代海でアサリを食べてしまうため駆除されたものです。そのチヌをおいしく食べてSDGsや食品ロス軽減について考えながら食品系は商品開発を行っています!!
 |
 |
| チヌをさばいています!(^^)! | スパイスを計量中… |
 |
 |
| 材料を炒めています! | 具材となるチヌを揚げています!! |
| 製造時の一コマです!(^^)! | |
【マリン校舎】(食品系)ビワ缶詰実習
5月15日(水)
天草の鬼池地区は、「びわ」の特産地として有名です。
そのため、本校は水産高校の時代から「びわ缶詰」の製造を行ってきました。
今、市販で「びわ缶詰」はなかなか見ることのできないレアな商品でとても希少です。
一般企業では種や実の内側にある薄皮をとるのが面倒なため製造されなくなっています。
生徒達が、一つ一つ丁寧に作った「びわ缶詰」をぜひご賞味ください!
 |
 |
| 製造方法について説明を聞いています | 青果にならないびわを安く譲っていただき加工します |
 |
 |
| 種や実の内側の薄皮を取り除きます | 薄皮の取り残しを取り除き缶に入るように実を切ります |
 |
 |
| 実を蒸してシロップを詰めていきます | 3か月ほど熟成させて販売をします!! |
【マリン校舎】(航海コース)熊本丸航海日誌 No.2
5月14日(火)~16日(木)
熊本丸は現在、長崎県の長崎港内に錨泊中です。
昨日は、長崎港内に移動予定だったため早めに釣獲実習を行い、ミズイカなどを釣ることができました。
釣った魚は、生徒達が自分でさばいて夕食時にいただきました。
また、錨泊中には当直も行い訓練記録簿を使って熊本丸乗組員から船舶職員の心得についてしっかりと教えてもらっています!!
| 〇乗船実習の様子〇 | |
| 〇5/14(火)の様子 | |
 |
 |
| 〇5/15(水)の様子 | |
 |
 |
| 〇5/16(木)の様子 | |
 |
 |
【マリン校舎】カッター操練&釣獲実習(水産海洋基礎)
5月14日(火)
1年海洋科学科の生徒達は、水産海洋基礎の実習でカッター操練と釣獲実習を行いました!
カッターとは、大型の船に搭載される救命艇のことをいい、本校では授業のほかに、部活動でもカッターを漕いでいます。カッターを漕いだ海洋航海コースの生徒達は苦労しながらも一生懸命漕いでいました。
また、釣獲実習にいった栽培・食品コースの生徒達はマダコやカサゴを釣り上げてうれしそうにしていました。
水産について興味をもって学ぶ第一歩になったことでしょう。
 |
 |
| 一生懸命カッターを漕ぎました!(^^)! | |
 |
 |
| 釣りの様子・・・ | 釣れた魚と一緒に記念写真!(^^)! |
【マリン校舎】(食品系)身の回りの微生物を観察しよう!
5月13日(月)
私達が日々生活するこの世の中には数多くの微生物がいます。
人の手には常在菌というたくさんの微生物がおり、空気中にも菌が存在しています。
そこで今回は、標準寒天培地を使って手の常在菌や空中落下菌を培養して観察しました。
培養した微生物は色や大きさも様々な微生物を観察することができました。
 |
 |
| 標準寒天培地の粉を計量しています | 蒸留水に標準寒天培地の粉を溶かします |
 |
 |
| 溶かした標準寒天培地を滅菌します | 培地で増殖した菌を観察中・・・ |
|
 |
| 手や空気中にいる細菌です | 観察結果をレポートにまとめています |
【マリン校舎】(航海コース)熊本丸航海日誌 No.1
5月11日(土)~13日(月)
熊本丸は現在、長崎県五島市富江湾に錨泊中です。
この3日間は、船が港に入るときロープの受け渡しに使うレッドという重りを遠心力を使って遠くに投げる練習や船の乗り降りする橋の網づくりを始めたりしました!
まだ実習が始まったばかりで戸惑うことも多いですが、実習を繰り返して立派な船舶職員になれるように頑張ってもらいたいです。
| ★実習の様子★ | |
| 〇5/11(土)の様子 | |
 |
 |
| 〇5/12(日)の様子 | |
 |
 |
| 〇5/13(月)の様子 | |
 |
 |
【マリン校舎】熊本日日新聞に「出港式」の様子が掲載されました
【マリン校舎】(食品系)新商品開発に向けて・・・~グリーンカレー編①~
5月9日(木)
マリン校舎食品系の3年生は今年「グリーンカレー」の商品開発を始めようとしています。
本日は、その第一歩として市販のグリーンカレーペーストを使用してカレーを作り、試食を行いました。
生徒達からは「辛いけどクセになる」や「もう少しうまみがあったほうがいいな~」など様々な意見が出ており、自分たちが作っていく商品のイメージを膨らませていました。
今後の商品開発情報を楽しみにお待ちください!!
 |
 |
| 原材料を計量しています | カレーに入れる魚をさばいています |
 |
 |
| ココナッツミルクを入れていきます | カレーを煮込んでいきます |
 |
 |
| 出来上がったカレーをつぎ分けていきます | 今日作ったグリーンカレーです |
【マリン校舎】(食品系)クリームパン・あんパン試作
5月8日(水)
マリン校舎食品系の卒業生には、製パン会社に就職した生徒も多くいます。
そこで、食品系では水産加工品以外にも食品全般について勉強し、職業学習も行っています。
本日は、クリームパンとあんパンの試作を通じて、発酵の原理や製造方法について学びました。
生徒達は、難しいと言いながらも真剣に取り組んでいました。
クリームパンとあんパンは上手にできたかな?
 |
 |
| カスタードクリームを手作りしています | 一つ一つ丁寧にあんこやカスタードを包みます |
 |
 |
| つやを出すために卵黄を塗っていきます | 某キャラクターも作られました! |
 |
 |
| 180℃のオーブンに入れます・・・ | 上手に焼きあがってくれたかな? |
【マリン校舎】熊本丸出港式
5月8日(水)
富岡港にて出港式を行いました。本日出港式に臨んだ3年海洋科学科海洋航海コースの生徒19名は、緊張感に包まれながらやる気に満ちた様子でした。熊本丸は、本校生徒や保護者、御来賓のみなさま、苓北中学校3年生、近隣保育園の園児などに見送られ出港しました。本日の1次航海を皮切りに、運航実務実習や沿岸漁業生産実習が始まります。
実習の様子は、随時更新予定です。



















※写真は、一部加工処理をしています。
【マリン校舎】(食品系)みなとオアシス富岡で販売を行いました!!
5月4日(土)
5/4(土)に富岡港周辺で行われたみなとオアシス富岡にて実習製品の販売を行いました!!
販売には、数多くのお客様が来てくださり販売は大盛況に終わりました!(^^)!
来てくださった皆様、ありがとうございました!
 |
 |
| 販売に向けて準備中… | 多数のお客様に製品をお買い上げいただきました!(^^)! |
 |
|
|
販売に来てくださった皆様、 ありがとうございました!! |
【マリン校舎】(食品系)実習製品販売のお知らせ
5月2日(木)
苓北町のサイト【https://reihoku-kumamoto.jp/kiji0031608/】
5月4日(土)に富岡港一帯にて行われる「第6回 春の行楽 みなとオアシス富岡フェア」にて実習製品販売を行います。皆様ぜひ、いらっしゃってください!!
 |
 |
| 販売する実習製品の一覧 | |













